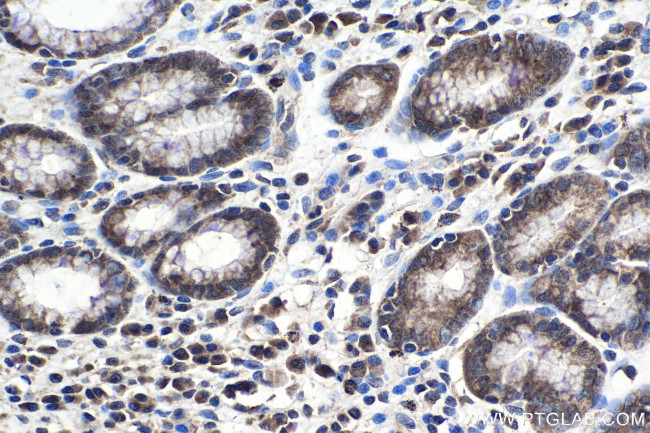
ELP2 Antibody in Immunohistochemistry (Paraffin) (IHC (P))

Search
Proteintech
ELP2 Polyclonal Antibody
{{$productOrderCtrl.translations['antibody.pdp.commerceCard.promotion.promotions']}}
{{$productOrderCtrl.translations['antibody.pdp.commerceCard.promotion.viewpromo']}}
{{$productOrderCtrl.translations['antibody.pdp.commerceCard.promotion.promocode']}}: {{promo.promoCode}} {{promo.promoTitle}} {{promo.promoDescription}}. {{$productOrderCtrl.translations['antibody.pdp.commerceCard.promotion.learnmore']}}
产品信息
13793-1-AP
种属反应
宿主/亚型
分类
类型
抗原
偶联物
形式
浓度
规格
纯化类型
保存液
内含物
保存条件
运输条件
产品详细信息
Immunogen sequence: AITGQSLNHV LCNQDSDLPE GATVPALGLS NKAVFQGDIA SQPSDEEELL TSTGFEYQQV AFQPSILTEP PTEDHLLQNT LWPEVQKLYG HGYEIFCVTC NSSKTLLASA CKAAKKEHAA IILWNTTSWK QVQNLVFHSL TVTQMAFSPN EKFLLAVSRD RTWSLWKKQD TISPEFEPVF SLFAFTNKIT SVHSRIIWSC DWSPDSKYFF TGSRDKKVVV WGECDSTDDC IEHNIGPCSS VLDVGGAVTA VSVCPVLHPS QRYVVAVGLE CGKICLYTWK KTDQVPEIND WTHCVETSQS QSHTLAIRKL CWKNCSGKTE QKEAEGAEWL HFASCGEDHT VKIHRVNKCA L
靶标信息
ELP2 regulates the ligand-dependent activation of STAT3. The protein acts as subunit of the RNA polymerase II elongator complex, which is a histone acetyltransferase component of the RNA polymerase II (Pol II) holoenzyme and is involved in transcriptional elongation. Elongator may play a role in chromatin remodeling and is involved in acetylation of histones H3 and probably H4.
仅用于科研。不用于诊断过程。未经明确授权不得转售。
篇参考文献 (0)
生物信息学
蛋白别名: elongation protein 2 homolog; Elongator complex protein 2; elongator protein 2; ELP2; SHINC-2; signal transducer and activator of transcription 3 interacting protein 1; signal transducer and activator of transcription interacting protein 1; STAT3-interacting protein 1; STATIP1; StIP1; unnamed protein product
基因别名: AU023723; ELP2; Epl2; MRT58; SHINC-2; STATIP1; StIP; StIP1
UniProt ID: (Human) Q6IA86, (Mouse) Q91WG4, (Rat) Q496Z0
Entrez Gene ID: (Human) 55250, (Mouse) 58523, (Rat) 307545